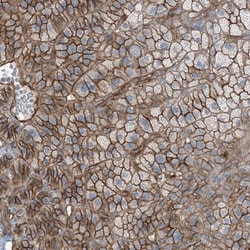
Invitrogen ZFP90 Polyclonal Antibody 100 &mu;L; Unconjugated:Antibodies,

missing translation for 'onlineSavingsMsg'
Learn More
Learn More
Invitrogen™ ZFP90 Polyclonal Antibody


Rabbit Polyclonal Antibody
Brand: Invitrogen™ PA556037
This item is not returnable.
View return policy
Description
Immunogen sequence: SEGEIQRPFY PDWKTRPEVK SSHLQQDVSE VSHCTHDLLH ATLEDSWDVS SQLDRQQENW KRHLGS Highest antigen sequence identity to the following orthologs: Mouse - 56%, Rat - 59%.
ZFP90 may function as a repressor or silencer protein, and most likely exerts its repressing activity upon zinc-dependent binding to DNA. It may be involved in proper spermatogenesis by repressing the expression of genes unnecessary or incompatible with the maintenance of a haploid cell state.
Specifications
| ZFP90 | |
| Polyclonal | |
| Unconjugated | |
| ZFP90 | |
| 6430515L01Rik; FIK; FOXP3-interacting KRAB domain-containing protein; KIAA1954; KRAB17; mKIAA1954; NK10; Nk10 expressed protein; Zfp64; Zfp83; Zfp90; zfp-90; ZFP90 zinc finger protein; zinc finger protein 476; zinc finger protein 756; zinc finger protein 83; zinc finger protein 90; Zinc finger protein 90 homolog; zinc finger protein NK10; ZNF756 | |
| Rabbit | |
| Antigen affinity chromatography | |
| RUO | |
| 146198 | |
| Store at 4°C short term. For long term storage, store at -20°C, avoiding freeze/thaw cycles. | |
| Liquid |
| Immunohistochemistry (Paraffin), Immunocytochemistry | |
| 0.3 mg/mL | |
| PBS with 40% glycerol and 0.02% sodium azide; pH 7.2 | |
| Q8TF47 | |
| ZFP90 | |
| Recombinant protein corresponding to Human ZFP90. Recombinant protein control fragment (Product #RP-95754). | |
| 100 μL | |
| Primary | |
| Human | |
| Antibody | |
| IgG |
Product Content Correction
Your input is important to us. Please complete this form to provide feedback related to the content on this product.
Product Title
Spot an opportunity for improvement?Share a Content Correction